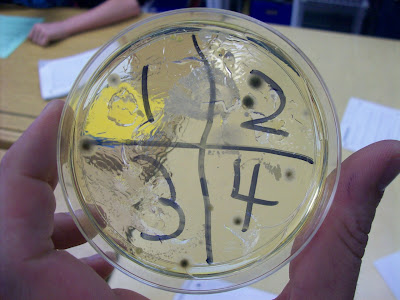

Let's start off with our lunch room, front office, and computer lab.
Let's start off with our lunch room, front office, and computer lab.1. Water fountain
2. Key board from sixth grade computer lab
3. Phone from the office (student use)
4. Lunch room key pad (student use)
 Next, revisit to the office and lunch room with stops in the sixth grade lab and restroom.
Next, revisit to the office and lunch room with stops in the sixth grade lab and restroom.1. Front office phone (student use)
2. Computer mouse from sixth grade computer lab
3. Lunch room key pad (student use)
4. Toilet seat (girls restroom)
Lastly, school library, toilet seat, and our own door handle.
Lastly, school library, toilet seat, and our own door handle.1. Toilet seat (boys restroom)
2. My classroom door handle
3. Library book marks
4. Library counter top
Overall we found that we live in a pretty disgusting world. There is no escaping germs and bacteria no matter where we go. Some students found bacteria in unlikely places, such as the library and bookmarks. There was also sampled locations that we expected lots of bacteria, but not to the extent we found, like our classroom pet the roaches. As we move forward we will be switching our focus from diversity of life to properties of matter as we come down the final stretch of the school year.
Mr. McClung






15 comments:
This is a great experiment to do as a class, you are right,germs and bacteria are everywhere we are even breathing it in!! Great work and good luck for your next study.
Hi Mr Clung's Sixth Grade World,
Those were interesting conclusions you showed using your petri dishes and bacteria. I was really surprised to see the amount of bacteria on the school phone that students use. Does that make your more conscious of what's clean and what's not?
Miss Lavakula and Room 10@Pt England School, N.Z
Yummmmmy, lunch anyone?
That was weird but very interesting. I love how you showed it.
This is so cool that you can watch your class live! THe experiment you are doing is similar to one I did at a summer camp at my school. It was a csi camp so we did it a little differently, not on bacteria but we used the same materials. Right now, I am taking life science and we are learning about the Chesapeake Bay, soon we will visit it! Enjoy your project and class!
hey mr. clung class! i think your blog is super cool! the experiment you guys are doing is so much fun! i remember doing it! even though it is kinda disgusting i loved doing it! also i love watching your class i think it is so coll i am able to do that!!!!!!!!!!!!!!!!!!!!!!
i Think this is a very cool and interesting experiment to do in class. I wish i was able to do that class to understand bacteria better. also i love how you have a live camera of your students.
That is a great idea for an experiment, I thought I knew how much bacteria were in the school, this might have saved me from getting sick! Congratulations on completing your experiment!
That was alot of bacteria and it was soooo gross looking but that was probably a supperdupper funtakular project. GOOD JOB jEVERYBODY.
I love the live webcame! awesome feature!
That was very interesting and it was a great example of a for sure A+ Project!!! Great job with your bacteria project, I remember doing that a couple years back, and it was really a lot of fun!!!
someone should have done the girls bathroom
That was a really good experiment, it shows that germs and bacteria are all around us, its just and unescapable fact. Really cool site by the way the live feed is awesome. Good job Mr. McClung
I think that it was kinda cool what you guys did about the germs and collecting it from places like the boys bathroom,office ,phone and other places.
awesome experiment. The Toilet seat seemed surprisingly clean.
Post a Comment